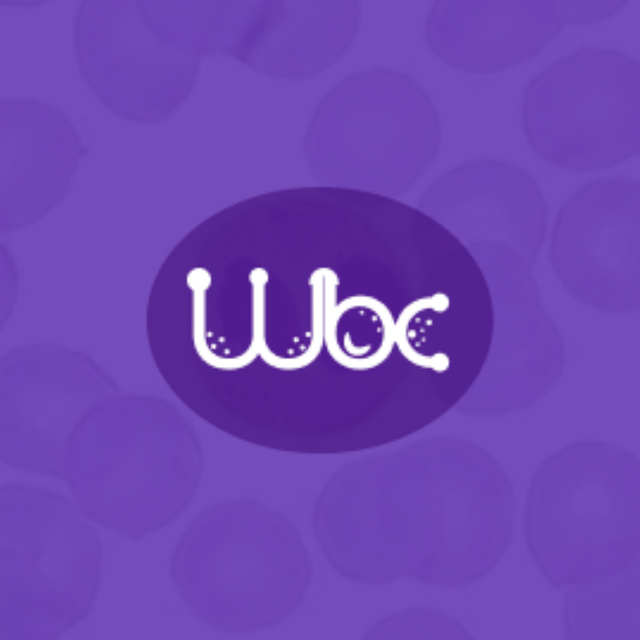

Esta página no es una página oficial de la aplicación ni de su desarrollador, sino una publicación editorial independiente creada con fines informativos y de comentario. Salvo que se indique expresamente lo contrario, ni la aplicación ni su desarrollador están afiliados, respaldados, patrocinados, autorizados ni conectados oficialmente con MWM, Apple, Google Play, el editor de la aplicación ni su desarrollador, y nada en esta página implica que la aplicación haya sido desarrollada utilizando los servicios de MWM. Todas las marcas comerciales, logotipos, capturas de pantalla y demás contenidos son propiedad de sus respectivos propietarios.
Leucogram | wbc counter
El asistente digital esencial para profesionales médicos y estudiantes. Reemplaza los contadores mecánicos tradicionales con una herramienta de alto rendimiento que ofrece retroalimentación háptica, guías de identificación visual y visualización de datos instantánea para informes hematológicos más rápidos y precisos.
Descargas
7K+Valoración
Total valoraciones
0Editor
Categoría
MedicalIdiomas
1Última versión
1.0.12Tamaño
50.4 MBFecha de lanzamiento
23 ago 2024Herramientas de Precisión para Hematología Moderna
Optimiza tu flujo de trabajo clínico con un contador diferencial digital diseñado para la precisión, la velocidad y el aprendizaje continuo.
Recuento sin Apartar la Vista del Microscopio
Utiliza retroalimentación háptica y de sonido personalizable para registrar células sin apartar la vista del ocular del microscopio.
Guía Celular Integrada
Elimina la incertidumbre durante las rotaciones con una biblioteca de identificación incorporada que presenta imágenes de alta calidad y consejos de diagnóstico.
Apps Similares
Apps mejor clasificadas en la misma categoría

国家医保服务平台
National Healthcare Security Administration

MyChart
Epic Systems Corporation

Doctolib - Your health partner
Doctolib

Pregnancy + | Tracker App
Philips Digital UK Limited

CVS Health
CVS Pharmacy

江苏医保云
Jiangsu Healthcare Security Bureau

UnitedHealthcare
UNITED HEALTHCARE SERVICES, INC.

京东健康
BEIJING JINGDONG 360 DU E-COMMERCE LTD.

Meu SUS Digital
Servicos e Informacoes do Brasil
Esta página no es una página oficial de la aplicación ni de su desarrollador, sino una publicación editorial independiente creada con fines informativos y de comentario. Salvo que se indique expresamente lo contrario, ni la aplicación ni su desarrollador están afiliados, respaldados, patrocinados, autorizados ni conectados oficialmente con MWM, Apple, Google Play, el editor de la aplicación ni su desarrollador, y nada en esta página implica que la aplicación haya sido desarrollada utilizando los servicios de MWM. Todas las marcas comerciales, logotipos, capturas de pantalla y demás contenidos son propiedad de sus respectivos propietarios.